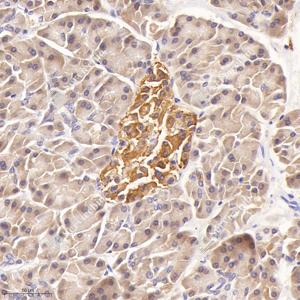

Anti-DPEP1/MDP Rabbit pAb
- 100 μL
产品信息
|
蛋白质全称 |
二肽酶1 |
|
别名 |
Dehydropeptidase I, DPEP1, hRDP, MBD1, MDP, Microsomal dipeptidase, RDP, Renal dipeptidase |
|
Uniprot ID |
P31428 |
|
免疫原 |
KLH偶联的小鼠DPEP1/MDP合成肽 |
|
抗体亚型 |
IgG |
|
纯化方式 |
亲和纯化 |
|
亚细胞定位 |
细胞膜, 细胞突起 |
应用
| 应用 | 物种 | 稀释 | 阳性样品 |
| IHC/IF 免疫组织化学/免疫荧光 | 人 | 1: 800-1: 2400 | 胰腺癌 |
背景
Hydrolyzes a wide range of dipeptides including the conversion of leukotriene D4 to leukotriene E4. Hydrolyzes cystinyl-bis-glycine (cys-bis-gly) formed during glutathione degradation. Possesses also beta lactamase activity and hydrolytically inactivates beta-lactam antibiotics.; Independently of its dipeptidase activity acts as an adhesion receptor for neutrophils recruitement from bloodstream into inflammed lungs and liver.
图像
|
|
IHC检测DPEP1/MDP蛋白(货号 GB114958). 样品: 人胰腺癌, 4%多聚甲醛 (货号G1101) 固定12-24小时. 抗原修复: Tris-EDTA抗原修复液(pH 9.0) (G1203), 98℃, 20分钟. —抗: 1: 800稀释, 4℃ 孵育过夜. 二抗: HRP标记山羊抗兔IgG (H+L) (货号GB23303), 1: 200稀释, 室温孵育1小时. |
储存
| 储存条件 | 在-20℃下储存一年, 避免反复冻融. |
| 储存缓冲液 | 含0.15% ProClin300防腐剂, 100 μg/mL牛血清白蛋白和50%甘油的磷酸盐缓冲液. |
注意:
1.本产品仅供研究使用.
2.建议用一抗稀释液(G2025)稀释本产品.
| 货号 | 名称 | 规格 | 价格 | 操作 |
|---|
| 货号 | 名称 | 规格 | 价格 | 操作 |
|---|